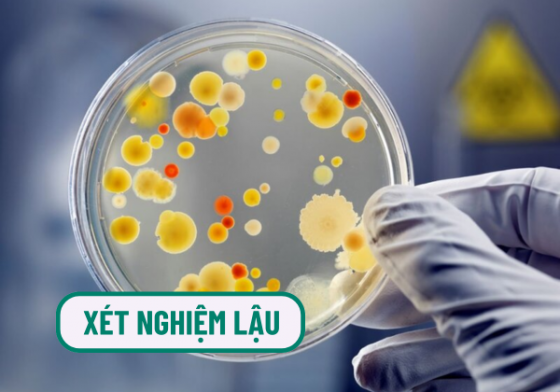
1759480263955963.png chua-benh-hieu-qua (29).png

Xét nghiệm bệnh lậu như thế nào? Chi phí bao nhiêu?
Xét nghiệm bệnh lậu là bước cần thiết để phát hiện và điều trị kịp thời căn bệnh xã hội nguy hiểm này. Khi tìm hiểu, người bệnh thường quan tâm đến quy trình, phương pháp, địa chỉ uy tín và đặc biệt là chi phí xét nghiệm bệnh lậu. Bài viết sau sẽ cung cấp thông tin đầy đủ giúp bạn chuẩn bị tốt trước khi thăm khám.
CÁC TRƯỜNG HỢP CẦN XÉT NGHIỆM BỆNH LẬU?
Lậu là một bệnh lý xã hội nguy hiểm do vi khuẩn Neisseria gonorrhoeae gây ra, chủ yếu lây truyền qua đường tình dục không lành mạnh. Bệnh có thể gây viêm nhiễm ở cơ quan sinh dục, hậu môn, mắt, họng và nếu không được phát hiện kịp thời có thể gây biến chứng vô sinh, viêm màng não, nhiễm trùng máu,…
Do đó, các trường hợp sau được khuyến cáo nên sớm thực hiện xét nghiệm lậu:
➤ Sau khi quan hệ tình dục không lành mạnh: Đặc biệt với bạn tình mới, người có nhiều bạn tình hoặc người nghi ngờ mắc bệnh xã hội.
➤ Xuất hiện triệu chứng bất thường: Như tiểu buốt, tiểu rắt, chảy mủ ở cơ quan sinh dục, đau khi quan hệ, ngứa vùng kín.
➤ Khi có bạn tình mắc bệnh lậu: Cần xét nghiệm sớm để kiểm tra tình trạng lây nhiễm.
➤ Phụ nữ mang thai nghi ngờ nhiễm lậu: Xét nghiệm giúp bảo vệ sức khỏe mẹ và thai nhi.
➤ Người từng mắc bệnh xã hội: Cần xét nghiệm định kỳ để theo dõi tái lại hoặc nhiễm chéo.
➤ Khám sức khỏe sinh sản: Trước khi kết hôn, mang thai hoặc điều trị vô sinh - hiếm muộn.
TÌM HIỂU CÁCH XÉT NGHIỆM BỆNH LẬU CHUẨN XÁC
Có nhiều loại xét nghiệm được sử dụng để sàng lọc, chẩn đoán bệnh lậu với các mẫu vật phẩm khác nhau như: xét nghiệm lậu bằng dịch tiết hay xét nghiệm lậu bằng nước tiểu. Dưới đây là những xét nghiệm phổ biến hiện nay để chẩn đoán bệnh lậu:
❖ Xét nghiệm nuôi cấy vi khuẩn
Mẫu vật phẩm là dịch được lấy từ âm đạo, trực tràng, mắt, cổ họng,... của người bệnh nghi ngờ mắc bệnh lậu, sau đó được nuôi cấy trong môi trường thuận lợi của loại vi khuẩn này.
Trong khoảng thời gian cụ thể (thường trung bình là khoảng 3 - 5 ngày), nếu trong mẫu bệnh phẩm có vi khuẩn lậu thì chúng sẽ sinh sôi, nhân lên số lượng nhanh và có thể xác định được.
❖ Xét nghiệm nhuộm gram tìm lậu cầu
Nhuộm gram là kỹ thuật sử dụng thuốc nhuộm chuyên biệt để làm nổi bật vi khuẩn lậu cầu, giúp quan sát dễ dàng hơn dưới kính hiển vi. Mẫu bệnh phẩm sử dụng trong xét nghiệm này là mẫu dịch niệu đạo, dịch ở âm đạo, cổ tử cung.
Với xét nghiệm nhuộm gram chẩn đoán bệnh lậu này, thời gian phân tích khá nhanh, kết quả có thể có trong 30 - 45 phút.
❖ Xét nghiệm PCR
Xét nghiệm PCR là kỹ thuật xét nghiệm cho kết quả nhanh, có thể chẩn đoán bệnh ở giai đoạn sớm. Mẫu bệnh phẩm được sử dụng là dịch niệu đạo ở nam giới, nước tiểu đầu dòng ở nam giới hoặc dịch âm đạo của nữ giới.
Độ nhạy và độ đặc hiệu của xét nghiệm này đạt tới khoảng 98%, được đánh giá là xét nghiệm chính xác.
Xét nghiệm PCR phù hợp với những bệnh nhân nghi ngờ mắc bệnh lậu nhưng chưa có triệu chứng.
CÁCH ĐỌC KẾT QUẢ XÉT NGHIỆM LẬU
Các xét nghiệm lậu đều có chung cách đọc kết quả là âm tính hoặc dương tính. Bao gồm cho cả xét nghiệm nhuộm gram, nuôi cấy vi khuẩn và PCR.
✧ Dương tính: Xác định tình trạng nhiễm vi khuẩn lậu, nghĩa là đã mắc bệnh lậu.
✧ Âm tính: Nghĩa là không tìm thấy vi khuẩn lậu tại thời điểm xét nghiệm. Nếu vẫn có triệu chứng của bệnh lậu thì cần làm thêm các xét nghiệm khác để xác nhận kết quả.
▶︎▶︎ LỜI KHUYÊN: Để nhận kết quả xét nghiệm lậu chính xác, bạn nên đến cơ sở y tế chuyên khoa có đầy đủ thiết bị hiện đại và đội ngũ bác sĩ giàu kinh nghiệm.
Tại đây, các xét nghiệm sẽ được thực hiện đúng quy trình, độ chính xác cao, tránh tình trạng sai lệch kết quả dẫn đến chẩn đoán và điều trị không đúng.
Không tự ý mua que test nhanh tại nhà hoặc xét nghiệm ở những nơi kém uy tín.
CHI PHÍ XÉT NGHIỆM BỆNH LẬU BAO NHIÊU?
Bảng giá xét nghiệm bệnh lậu chưa có con số cụ thể khi bác sĩ chưa thực hiện thăm khám, xét nghiệm và điều trị. Giá xét nghiệm lậu sẽ phụ thuộc vào nhiều yếu tố khác nhau như:
✔ Chi phí khám ban đầu: Bao gồm thăm khám, hỏi bệnh, kiểm tra vùng kín trước khi xét nghiệm.
✔ Tình trạng bệnh: Bệnh nhẹ, ít triệu chứng thì xét nghiệm đơn giản; bệnh nặng cần nhiều xét nghiệm nên chi phí cao hơn.
✔ Tay nghề bác sĩ: Bác sĩ giỏi, nhiều kinh nghiệm thì chi phí thường cao hơn nhưng kết quả chính xác hơn.
✔ Cơ sở y tế: Nơi uy tín, máy móc hiện đại sẽ có chi phí cao hơn so với cơ sở kém chất lượng.
✔ Dịch vụ y tế: Nếu chọn lấy mẫu và trả kết quả tại nhà thì chi phí sẽ cao hơn thông thường.
XÉT NGHIỆM LẬU CHÍNH XÁC VÀ TIẾT KIỆM TẠI BÌNH DƯƠNG
Xét nghiệm đúng nơi, đúng phương pháp sẽ giúp phát hiện sớm bệnh và điều trị hiệu quả, tránh biến chứng nguy hiểm. Tại tỉnh Quảng Ngãi, Phòng Khám Chuyên Bệnh Xã Hội Bình Dương là địa chỉ được nhiều người bệnh tin tưởng khi có nhu cầu xét nghiệm và điều trị bệnh lậu.
Ưu điểm khi xét nghiệm lậu tại Phòng Khám Chuyên Bệnh Xã Hội Bình Dương:
✪ Trang thiết bị hiện đại: Ứng dụng các kỹ thuật xét nghiệm tiên tiến, cho kết quả nhanh và chính xác.
✪ Đội ngũ bác sĩ giỏi: Bác sĩ chuyên khoa giàu kinh nghiệm trong thăm khám và điều trị các bệnh xã hội.
✪ Quy trình xét nghiệm chuyên nghiệp: Thực hiện đúng quy chuẩn y tế và bảo mật thông tin.
✪ Dịch vụ đặt lịch nhanh: Hỗ trợ tư vấn – đặt hẹn trực tuyến 24/7, không cần chờ đợi lâu.
✪ Chi phí hợp lý – công khai: Mức giá xét nghiệm và điều trị được niêm yết minh bạch, phù hợp với nhiều đối tượng.
TIN ƯU ĐÃI ĐẶC BIỆT: Nhằm tạo điều kiện cho người bệnh chủ động đi khám, giảm bớt gánh nặng tài chính, Phòng Khám Chuyên Bệnh Xã Hội Bình Dương hiện đang triển khai chương trình ưu đãi khi đặt hẹn trước qua Hotline 0933.833.115 hoặc đăng ký trực tiếp qua website [TẠI ĐÂY]:
 Giảm 30% chi phí điều trị chuyên sâu
Giảm 30% chi phí điều trị chuyên sâu
 Được chọn bác sĩ chuyên khoa trực tiếp thăm khám
Được chọn bác sĩ chuyên khoa trực tiếp thăm khám
Nhanh tay đặt lịch ngay để không bỏ lỡ ưu đãi có hạn!
Lưu ý quan trọng: Chương trình chỉ áp dụng cho bệnh nhân đặt lịch trước online. Nếu không đăng ký, bạn sẽ phải thanh toán toàn bộ chi phí theo giá gốc!
Hy vọng qua bài viết trên, người đọc đã viết được khi nào cần xét nghiệm bện lậu và xét nghiệm lậu ở đâu chính xác. Chủ động điều trị sớm để bảo vệ sức khỏe bản thân và gia đình. Liên hệ đặt lịch khám ngay hôm nay nhận ưu đãi khám chữa bệnh hấp dẫn.
Gói khám nam khoa
- 1 Bệnh nhân 1 bác sĩ
- Thông tin bảo mật
Khám sinh lý nam giới
- Bác sĩ chuyên môn cao
- Trang thiết bị đạt chuẩn bộ Y tế
Gói khám bệnh xã hội
- Tận tâm, nhiệt tình
- Chăm sóc chu đáo
Ưu đãi giảm
- Phí điều trị


PHÒNG KHÁM ĐẠT CHUẨN BỘ Y TẾ
quy trình thăm khám

0933.833.115
0933.833.115 Đặt lịch
Đặt lịch Tư vấn
Tư vấn Zalo
Zalo